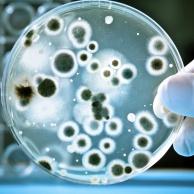
Bakterienkultur und Mikropsie

Untersuchungen - Blut, Lymphen, Drüsen
Bakterienkultur und Mikropsie
Bakterienkultur und Mikroskopie dienen dem Nachweis von Krankheitserregern wie Bakterien oder Pilzen. Je nach Infektion und dem Ort der Entzündung lassen sich über Blut, Eiter, Ausscheidungen oder einen Keime nachweisen, indem sie auf speziellen Nährböden ...

Blutdruckmessung
Die Blutdruckmessung ist eine einfache und schmerzlose Methode zur Untersuchung der Herz-Kreislauf-Funktion. Dabei wird der Druck des Blutes auf die Schlagadern gemessen. Der Blutdruckwert wird in einen maximalen (Systole) und einen minimalen Wert (Diastole) ...

Blutuntersuchung
Eine Blutuntersuchung ist die Untersuchung des Vollblutes oder Serums (Blut ohne feste Blutbestandteile) auf verschiedene Stoffe, die im Blut transportiert werden. Im Blut befinden sich viele verschiedene Substanzen wie Hormone, Vitamine und ...

Blutzuckermessung
Die Blutzuckermessung ist eine Messung des Zuckers (Glukose) im Vollblut oder Blutplasma. Der Wert liegt im Vollblut normalerweise niedriger als im Plasma, da das Volumen des Vollblutes größer ist: Vollblut : 55 bis 90 mg/dl (3,1 bis 5,0 mmol/l) Blutplasma : ...

Brust-Selbstuntersuchung
Die Brustselbstuntersuchung dient der -Früherkennung und wird von der Frau selbst durchgeführt. Ein großer Teil der größeren Tumore lässt sich durch die Selbstuntersuchung entdecken, allerdings weniger häufig Tumore, die kleiner als 2 cm sind. Wie funktioniert ...

Harnuntersuchung
Die Harnuntersuchung ist eine Überprüfung des Urins, der über die Harnwege ausgeschieden wird. Die physikalisch-chemische Zusammensetzung und die Betrachtung unter dem Mikroskop lassen Rückschlüsse auf zugrunde liegende Erkrankungen zu. Wie funktioniert eine ...

Pleurapunktion
Zwischen Rippenfell und Lungenfell befindet sich ein Spalt, der Pleuraraum. Flüssigkeit in diesem Raum, ein Pleuraerguss, lässt sich punktieren. Wie funktioniert die Pleurapunktion? Unter oder ohne Ultraschallkontrolle lässt sich eine Nadel durch Haut, Fett ...

Röntgenuntersuchung der Gefäße (Angiographie, CT-Angiographie, MR-Angiographie, DSA)
Die Angiografie dient der radiologischen Darstellung von Gefäßen, Arterien und Venen, um krankhafte Veränderungen zu erkennen. Für die Untersuchung ist ein Kontrastmittel notwendig. Die Untersuchungen werden häufig mit einem Katheter durchgeführt, sodass sich ...

Szintigraphie
Die Szintigrafie ist ein bildgebendes, nuklearmedizinisches Untersuchungsverfahren. Schwach radioaktive Substanzen (Radionuklide) machen Stoffwechselvorgänge im Körper sichtbar, sodass sich Durchblutung und Funktion von Geweben beurteilen lassen. Wie ...

Ultraschall der Schilddrüse
Ein Ultraschall der Schilddrüse oder eine Schilddrüsen-Sonographie ist eine bildgebende Untersuchung. Sie lässt Aussagen zur Größe und Beschaffenheit des hormonproduzierenden Organs zu und ist in Zusammenhang mit einer aussagekräftig. Wie funktioniert die ...
News zum Thema Blut, Lymphen, Drüsen
Zimt hilft gegen Zucker
Studien haben gezeigt, dass Zimt in Kombination mit anderen Vitalstoffen in der Lage ist, die Insulinempfindlichkeit rascher zu steigern, als dies mit einer gesunden Ernährung und regelmäßiger Bewegung alleine ...
weiterlesenZusammenhang zwischen Osteoporose und Homocysteinwert
Amerikanische und niederländische Forscher haben herausgefunden, dass bereits bei mäßig erhöhtem Homocystein-Spiegel im Blut die Häufigkeit von Knochenbrüchen um das zwei- bis vierfache Maß ...
weiterlesenWarum werden wir rot?
Treten unangenehme und peinliche Situationen auf, steigt uns oft die Schamröte ins Gesicht. Diese unwillkürliche und nicht steuerbare Hautreaktion ist im Grunde Ausdruck einer ...
weiterlesenWelche Therapie bei Gelenk- oder Muskelschmerzen?
Für Personen mit Gelenk- oder Muskelschmerzen gibt es verschiedene Behandlungsmöglichkeiten, allerdings ist nicht jede Therapie für jeden Schmerzgeplagten gleichermaßen ...
weiterlesenPlaster als Blutzuckermessgerät
Das englische Unternehmen Nemaura Medical hat ein Pflaster entwickelt, dass gänzlich ohne jeden Hauteinstich in der Lage ist, den Glukosewert von Diabetespatienten zu ermitteln ...
weiterlesenSchutz für die Bauchspeicheldrüse
Warum wird die Anzahl der Menschen, die an Diabetes vom Typ 2 erkranken, immer höher?
Zum einen liegt das an unserer Ernährung ...
weiterlesenStatine können depressiv machen
Schon länger wird vor Arzneimitteln gewarnt, die meist ohne Bedenken bei bestimmten gesundheitlichen Problemen verschrieben werden, obwohl es schon längst Belege gibt, dass sie mehr ...
weiterlesenNatürliche Hilfen zur Cholesterinsenkung
Gerade in den kalten Winterwochen ist die Gefahr groß, sich beim Essen etwas mehr zu gönnen und zu viel Fett zu sich zu nehmen. Daher ist es nicht erstaunlich, wenn gerade im Winter ...
weiterlesenWas ist bei Osteoporose wirklich wichtig?
In den letzten zwanzig Jahren hat die Häufigkeit von osteoporotischen Hüftfrakturen um beinahe zwei Drittel zugenommen. Dies wurde auf dem Orthopädenkongress in Prag alarmierend deutlich gemacht ...
weiterlesenWundheilung von der Tageszeit abhängig?
Neueste Forschungen haben ergeben, dass die biologische innere Uhr die Wundheilung beeinflusst. Maßgeblich für die Heilung von Hautverletzungen ...
weiterlesen